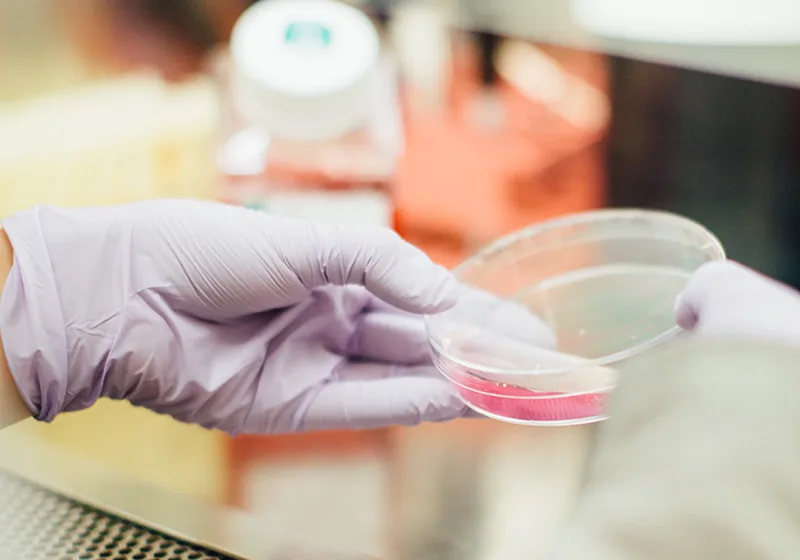
Scientific research centers.

Nanosensor Platform for Advanced DNA and RNA Analysis
Step beyond digital PCR with fast, portable, and precise nanosensor diagnostics.
Technology
Our innovative technology harnesses the power of carbon nanotube sensors to detect DNA hybridisation with unparalleled sensitivity
How It Works
DNA probes are immobilised on the sensor surface, allowing them to bind complementary DNA or RNA sequences in a sample. This hybridisation induces measurable changes in the sensor’s electrical properties, enabling the detection of even trace amounts of target molecules.
What makes it unique
Unlike traditional PCR-based methods, our system eliminates the need for fluorescence detection, enzymatic reactions, or optical components. This makes it portable, robust, and free from the need for calibration.
Product
Powerful platform.
Device, Nanosensors, Software.

Device. Portable, reliable, and fast.
Our compact device is optimized for rapid diagnostics in the lab or field. It’s vibration-resistant, calibration-free, and performs analysis in under 30 minutes.

Nanosensors. Innovative for every sample.
Our carbon nanotube nanosensors use DNA probes for high sensitivity, enabling the detection of extremely low concentrations of target molecules. They resist inhibitors and work effectively with degraded DNA samples.

Software. Intuitive and powerful analytical tools.
Our software simplifies data analysis. From SNP detection to liquid biopsy, it empowers clinicists and researches to make quick and optimal decisions.
Solutions
Applications
of Nucleotica Platform.

Cardiology.

Oncology.

Bacteriology.

Virology.
Solutions for businesses
Custom expertise.
Delivering tailored Innovations with our technology
Custom assay development.
Design and manufacture of devices tailored to your specific requirements, including fully custom instruments and individual units.
Modification or customization of existing equipment to optimize your processes and enhance performance.

We developed the high-precision device Nucleotica Sens 6
Scientific research and support.
Full-cycle project execution, including research design, assay development, and data analysis.
Advanced services such as PCR, NGS, and microbiome studies to meet your scientific needs.
Preparation of detailed reports, statistical analyses, and publication drafts to support your work.
Integration in labs and medical centers.
Helping B2B clients incorporate cutting-edge technologies into their existing infrastructure.
Providing training seminars and expert consultations tailored to your goals.

Our platform is already assisting laboratories in their research.
Partnership
We welcome scientific and research partnerships
Scientific research centers.
Collaborating on groundbreaking studies and technology development.
Providing expertise and resources to achieve mutual research goals.

Medical and biotech institutes.
Supporting research in diagnostics, treatment development, and bioinformatics.
Offering custom solutions for molecular biology, genomics, and microbiome studies.

Laboratories.
Partnering with diagnostic and research labs to optimize workflows and implement advanced technologies.
Delivering tailored tools, reagents, and methodologies to enhance lab capabilities.

Other industry players.
Engaging with pharmaceutical companies, healthcare providers, and startups to bring innovative ideas to life.
Co-developing solutions that meet the evolving needs of the medical and biotech industries.
Publications
Explore our groundbreaking research published in leading journals and presented at international conferences.
High-sensitivity label-free electrochemical genosensors for carbon nanotube plasmon-assisted detection of somatic mutations in nucleic acids from formalin-fixed paraffin-embedded tissues
Microchemical Journal 208 (2025) 112234 12p.
V.P. Egorova, H.V. Grushevskaya, N.G. Krylova, E.V. Vaskovtsev, A.S. Babenka, I.V. Anufreyonak, S.Yu. Smirnov, G.G. Krylov.
A single-molecule label-free identification of single-nucleotide colorectal-cancer-DNA polymorphism using impedance spectroscopy of self-redox-active decorated carbon nanotubes
Semiconductors, Vol. 54, no. 14, p. 1873–1876 (2020)
V.P. Egorova, H.V. Grushevskaya, A.S. Babenka, R.F. Chakukov, N.G. Krylova, I.V. Lipnevich, E.V. Vaskovtsev.
Nanopore-Penetration Sensing Effects for Target DNA Sequencing via Impedance Difference Between Organometallic-Complex-Decorated Carbon Nanotubes with Twisted Single-Stranded or Double-Stranded DNA
Advanced Nanomaterials for Detection of CBRN. NATO Science for Peace and Security Series A: Chemistry and Biology. / J. Bonca, S. Kruchinin (eds.) Springer, Dorchester, Chapter 17, p. 247-258 (2020)
A. S. Babenko, H. V. Grushevskaya, N. G. Krylova, I. V. Lipnevich, V. P. Egorova, R. F. Chakukov
Carbon nanotubes as a high-performance platform for target delivery of anticancer quinones
Current Pharmaceutical Design, Vol. 24 (43), p. 5207–5218 (2018)
H.V. Grushevskaya, N.G. Krylova
Contact us
Reach out to start your next innovation today.



